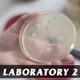
Laboratory 2 Laboratory 2 - VideoHive Item for Sale

Science -> Laboratory
-
16 Sales $10
-
56 Sales $11
-
2 Sales $10
-
2 Sales $10
-
2 Sales $11
-
4 Sales $10
-
2 Sales $10
-
14 Sales $10